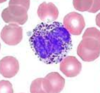
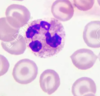
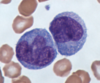
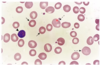

sitios de hematopoyesis
- saco vitelino embrionario
- higado fetal y bazo
- medula osea (huesos largos)
- craneo, pelvis, esternon, costillas y vertebras
Si produces hematopoyesis en otro sitio son enfermedades de la médula ósea hematopoyeticos extramedularres
periodos de desarrollo de hematopoyesis
- fase mesoblastica: hematopoyesis extraembrionaria y extramedular
- hematopoyesis medular
la hematopoyesis extraembrionaria se produce en _, de la semana _ de gestacion
saco vitelino
2-6 de gestacion
la hematopoyesis extramedular se produce en _, desde _ de gestacion
higado y bazo
3-9 mes
conjunto de sustancias quimicas, hormonales y diversos tipos celulares (endoteliales, lin T, macrofagos, cel reitculares y adipocitos) que se encargan de mantener un adecuado ambiente para el desarrollo de las celulas hematopoyeticas
microambiente hematopoyetico
qué sucede si se altera el microambiente hematopoyetico?
pueden presentarse deficiencias celulares agudas, cronicas, neoplasias, etc.
factor estimulante de colonias que no se produce en hueso, si no en riñon (en las células yuxtaglomerulares)
eritropoyetina
Marcador de la célula madre hematopoyética
CD34
La célula madre pluripotente tiene las características de: *PREGUNTA DE EXAMEN
- actividad de autorenovación: ella sola evita su muerte
- capacidad de división: da más células
- capacidad de diferenciación: madura a distintas líneas celulares

que es la mielopoyesis?
produccion de mielocitos

- granulocitos–> son neutrófilos, eosinófilos y basófilos
- Eritrocitos
- Plaquetas
- monocitos
cambios morfológicos para visualizar que una célula de la serie eritroide está madurando
- disminución del tamaño nuclear
- condensación progresiva de la cromatina y desaparición de nucleolos
- pérdida de la basofilia citoplasmática
- adquisición acidófila por Hb
fases por las que pasan los globulos rojos y que sucede en cada una?
- eritroblasto ortocromático: expulsión de núcleo
- reticulocitos: síntesis de ARN, proteínas y Hb
- eritrocito o hematíe: captación de O2 y su transporte a los tejidos

cómo se le llama al macrofago en higado
celula de Kupffer
quién genera a las plaquetas?
los megacariocitos
V/F: los megacariocitos salen a sangre periferica
falso, se quedan en la MO
donde se producen los osteoclastos?
MO
En que parte del hueso ocurre la hematopoyesis medular?
MO roja: Contiene masas deestromade tejido conectivo reticular que sostienen las CFC y su progenie (loscordones hematopoyéticos)
ambiente especifico para el desarrollo de cada tipo celular que interviene en el proceso de diferenciacion y ofrece a las celulas soporte fisico y punto de adhesion
nicho
es secretada por las celulas del estroma, formada por fibronectina, laminina, colageno y glucosaminoglucanos, proporcionan el sustrato al que se adhieren los progenitores mieloides y eritroides
matriz extracelular
mecanismos de interaccion de la matriz extracelular en la hematopoyesis
- accion directa de los factores de crecimiento de la membrana de la celula del estroma
- accion de los factores de crecimiento localizacos en la matriz extracelular
factores esitmulantes de colonias
- eritropoyetina (EPO)
- factor estimulante de colonias granulociticas (G-CSF)
- factor estimulante de colonias granulociticas-macrofagicas (GM-CSF)
quién se encarga de la regulacion de la hematopoyesis?
- microambiente
- factores de crecimiento
- matriz extracelular
- receptores que median adhesion, transmision de señales de otras celulas, de factores de crecimiento y de la matriz
proceso de formacion de un eritrocito (fases)
- proeritroblasto
- eritroblasto basofilo
- eritroblasto policromatico
- eritroblasto otrocromatico
- rerticulocito
- hematie o eritrocito

120 días es la vida media de un eritrocito
cambios morfológicos para visualizar que una célula de la serie granulopoyetica está madurando
- reduccion relacion nucleo-citoplasma
- desaparicion de los nucleolos-maduracion de la cromatina
- desaparicion de basofilia citoplasmatica
- granulacion primaria (promielocito)
- granulacion secundaria o especifica (neutrofila, eosinofila, basofila) en mielocito